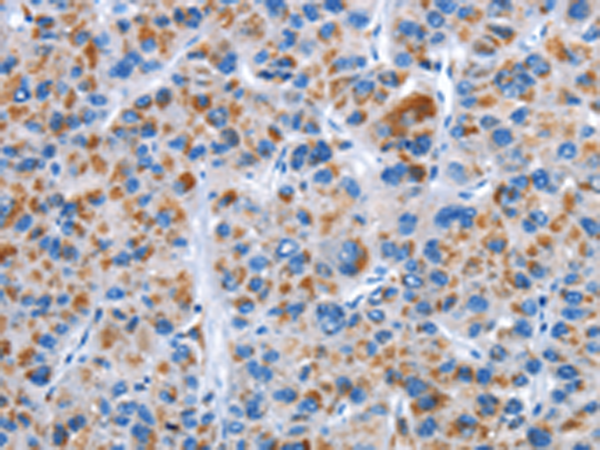
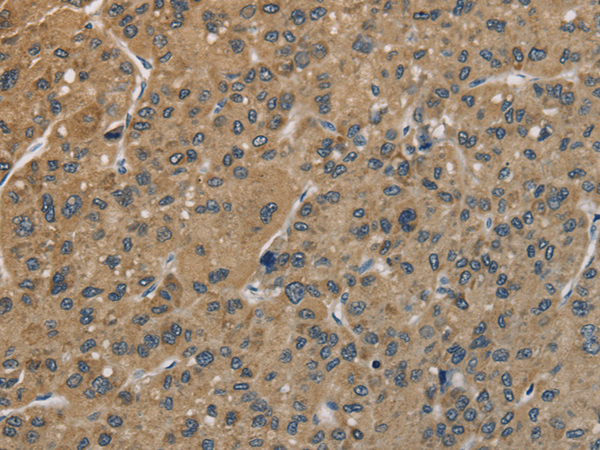

-
分类: 科研抗体货号: P01202别名: LAP; CPAP; LIP1; BM032; MCPH6; SASS4; SCKL4; Sas-4; CENP-J应用: IHC反应种属: Human, Mouse
-
分类: 科研抗体货号: P01208别名:应用: IHC反应种属: Human, Mouse, Rat
-
分类: 科研抗体货号: P01260别名: CP4Y; CYP4A2; CYP4AII; CYPIVA11应用: WB,IHC反应种属: Human
-
分类: 科研抗体货号: P01201别名: PANE1; CENP-M; C22orf18; bK250D10.2应用: IHC反应种属: Human
-
分类: 科研抗体货号: P01254别名: CYP11A; CYPXIA1; P450SCC应用: WB反应种属: Human
-
分类: 科研抗体货号: P01200别名: BM039; CENP-N; ICEN32; C16orf60应用: WB,IHC反应种属: Human
-
分类: 科研抗体货号: P01247别名: PIR121应用: WB,IHC反应种属: Human, Mouse
-
分类: 科研抗体货号: P01195别名: p18; INK4C; p18-INK4C应用: WB,IHC反应种属: Human, Mouse
-
分类: 科研抗体货号: P01244别名: CF5; WID; RINF; HSPC195应用: WB,IHC反应种属: Human, Mouse, Rat
-
分类: 科研抗体货号: P01194别名: C53; IC53; LZAP; HSF-27; MST016; PP1553; OK/SW-cl.114应用: WB,IHC反应种属: Human, Mouse, Rat

鄂公网安备42018502007531号
鄂公网安备42018502007531号

